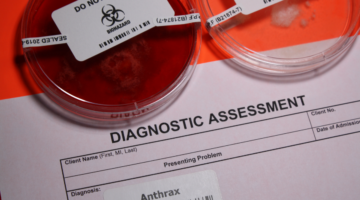
Anthrax : comment se protéger et traiter la maladie ?

Glechoma Hederacea 5CH granules homéopathie Boiron
Glechoma Hederacea 5 CH Tubes
Médicament enregistré : EH00568
Inscrit à la pharmacopée
Origine : Végétale
Prix public TTC : le prix des médicaments homéopathiques est librement défini par le pharmacien en ligne.
Le Glechoma hederacea en homéopathie offre une alternative naturelle pour le traitement de conditions respiratoires et digestives. Disponible en tubes à 5 CH, ce remède est une option sûre et efficace pour ceux qui recherchent des solutions homéopathiques pour améliorer leur bien-être général. Comme toujours, il est recommandé de consulter un professionnel de santé qualifié pour obtenir des conseils personnalisés et un traitement adapté à vos besoins spécifiques.
Indications et Posologie
Les médicaments homéopathiques peuvent être utilisés dans divers symptômes, il n'est donc pas possible de déterminer les indications et la dose d'une préparation spécifique.
Le médecin homéopathe choisit le médicament approprié, la dilution et le dosage appropriés à l'état de santé du patient et des symptômes caractéristiques.
Applications Thérapeutiques
Le Glechoma hederacea en homéopathie est principalement indiqué pour le traitement des affections respiratoires et digestives :
- Affections respiratoires : Il est utilisé pour soulager les symptômes de bronchite, notamment la toux grasse et les difficultés respiratoires. Ses propriétés expectorantes aident à fluidifier et à expulser les mucosités des voies respiratoires.
- Santé digestive : Le Glechoma hederacea peut également être bénéfique pour améliorer la digestion, traiter les ballonnements, et soulager les symptômes de l'indigestion. Ses effets anti-inflammatoires contribuent à réduire l'inflammation du tractus gastro-intestinal.
- Propriétés anti-inflammatoires : Utilisé pour ses effets bénéfiques sur diverses formes d'inflammation, il peut aider à réduire l'inflammation des articulations et soutenir la santé musculosquelettique.
Glechoma Hederacea 5CH : Un Remède Homéopathique pour les Affections ORL et Gastro-entérologiques
Utilisation en O.R.L.
Glechoma Hederacea 5CH, sous forme de granules, est un médicament homéopathique couramment utilisé pour traiter diverses irritations de la sphère O.R.L., telles que la pharyngite, la trachéite, et la laryngite. Ce remède est particulièrement efficace pour apaiser la toux et réduire l'inflammation de la glande sous-maxillaire, offrant ainsi un soulagement significatif aux patients souffrant de ces affections.
Avantages en Gastro-entérologie
En gastro-entérologie, Glechoma Hederacea est recommandé pour traiter les cas de diarrhées acides, souvent accompagnées d'hémorroïdes. Le médicament aide à normaliser la digestion et à apaiser l'irritation intestinale, contribuant ainsi à améliorer le confort et la qualité de vie des personnes affectées.
Conseils d'Utilisation pour une Meilleure Efficacité
Pour une utilisation optimale de Glechoma Hederacea 5CH, il est conseillé de prendre 5 granules, selon les besoins ou les recommandations d'un professionnel de santé. Il est préférable de prendre les granules à distance des repas pour assurer une meilleure absorption des principes actifs.
Conseils d'utilisation et mode d'emploi
Il est conseillé de ne pas toucher avec les doigts les granules homéopathiques.
Utiliser un dentifrice sans menthe (du type Homéodent Boiron, dentifrice compatible avec la prise de granules homéopathiques).
Combien de temps faut-il pour voir une amélioration avec Glechoma Hederacea 5CH ?
Bien que les résultats puissent varier selon l'individu et la gravité des symptômes, une amélioration peut souvent être observée après quelques jours d'utilisation régulière.
Y a-t-il des effets secondaires à l'utilisation de Glechoma Hederacea 5CH ?
Glechoma Hederacea 5CH est généralement bien toléré et les effets secondaires sont rares en homéopathie. Si vous observez des symptômes inhabituels, il est important de consulter un professionnel de santé.
Peut-on utiliser Glechoma Hederacea 5CH en complément d'autres traitements ?
Oui, Glechoma Hederacea 5CH peut être utilisé en complément d'autres traitements médicaux. Il est toujours prudent de consulter un professionnel de santé pour discuter de cette combinaison afin d'assurer une approche intégrée et sécuritaire du traitement des symptômes.
Glechoma Hederacea 5CH est-il adapté à tous les âges ?
Glechoma Hederacea 5CH peut être utilisé par des personnes de tous âges. Cependant, une consultation avec un professionnel de santé est recommandée pour confirmer la posologie et l'adéquation du traitement, en particulier pour les enfants et les personnes âgées.
Conditionnement et contenance
Le Glechoma hederacea, communément appelé Lierre terrestre, est une plante médicinale utilisée depuis des siècles pour ses multiples vertus thérapeutiques. En homéopathie, cette plante d'origine végétale est préparée sous forme de tubes à 5 CH et est reconnue dans la Pharmacopée française et européenne. Cet article explore les caractéristiques, la préparation, et les applications thérapeutiques du Glechoma hederacea en homéopathie.
Origine et Composition
Le Glechoma hederacea est une plante rampante de la famille des Lamiacées, souvent trouvée dans les zones ombragées et humides à travers l'Europe. En homéopathie, elle est utilisée pour ses propriétés expectorantes, anti-inflammatoires, et comme aide digestive. Son inscription à la Pharmacopée française et européenne témoigne de son utilisation traditionnelle et de son acceptation dans les traitements médicaux.
Formes de Préparation
Tubes : Le remède est disponible en granules homéopathiques à la dilution de 5 CH, une concentration souvent utilisée pour des traitements modérés et pour un usage régulier. Les granules permettent une administration facile et sont adaptées pour un large éventail de patients, y compris ceux qui préfèrent une approche douce et naturelle.
Précaution d'utilisation
Mise en garde
Contient de la sacchararose.
Donner des granules homéopathique aux bébés et aux enfants
Pour les granules ou les gouttes alcoolisées les dissoudre dans 100ml d'eau. Les granules étant très longs à dissoudre, il est nécessaire de préparer à l'avance votre mélange.
Homéopathie et grossesse
Les médicaments homéopathiques n'ont aucune toxicité chimique, ni contre indication, ni interaction avec d'autres médicaments, ni d'effet indésirable lié à la quantité de produit ingérée.Les femmes enceintes peuvent se soigner sans risque connu pour elles et leur futur enfant, mais il est préférable de demander conseils.
Fréquence d'utilisation de l'homéopathie
Dans les affections aigues, il est conseillé de prendre les remèdes homéopathiques toutes les heures jusqu'à amélioration des symptômes. Dès lors, il faut espacer les prises, 3 ou 4 fois par jour, puis arrêter progressivement.
Dans les affections chroniques, les remèdes en basse dilution (> à 9CH) se prennent 1 à 2 fois par jour, les remèdes de fond se prennent 1 fois par semaine, voire 1 fois par mois. Cette décision appartient à l'homéopathe.
Conduite à tenir en l'absence d'amélioration dans les 24 heures
Certaines pathologies ne peuvent pas être traitées en homéopathie par simple automédication. Leur gravité requiert un conseil médical pouvant être délivré par un médecin homéopathe. Ce médecin jugera si votre état peut être soigné par homéopathie seule ou si votre traitement doit être supplémenté par de l'allopathie.